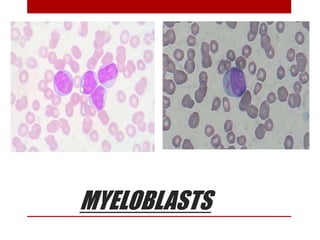
MYELOBLASTS
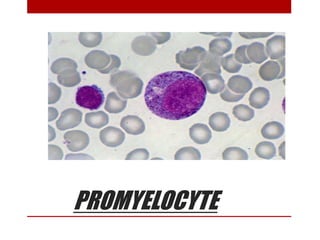
PROMYELOCYTE
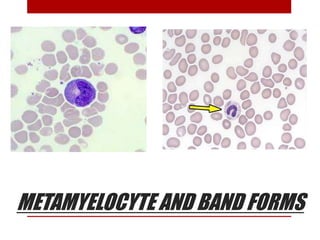
METAMYELOCYTE AND BAND FORMS

This document provides information about bone marrow examination. It discusses:
1. Bone marrow is located within bone cavities and contains hematopoietic cells, sinusoids, fibroblasts, fat cells, and macrophages. There are two types - red (active) marrow and yellow marrow.
2. Hematopoietic cells are arranged between sinusoids and supported by fibroblasts. Erythroid precursors cluster near sinusoids while granulocytes are near bone. Megakaryocytes are near sinusoid walls.
3. Bone marrow aspiration and biopsy are the main examination methods and each provides different information. Aspiration assesses cell morphology while biopsy studies architecture and fibrosis. Indications